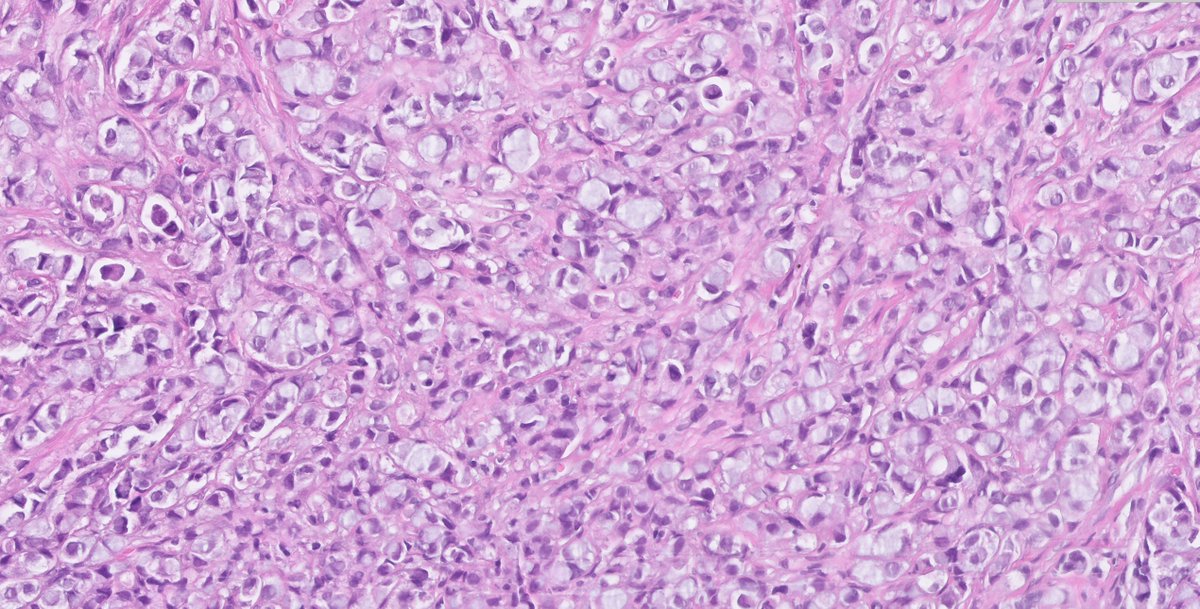
1/  #PathTwitter what is your understating on this skeletal metastasis in an elderly female?  #pathology  @smlungpathguy  @natasharekhtman

1/ #PathTwitter what is your understating on this skeletal metastasis in an elderly female? 
#pathology
@smlungpathguy @natasharekhtman

#pathology
@smlungpathguy @natasharekhtman

2/ #CUP
3/ #IHCpath
7/ So indeed this was a metastatic breast carcinoma and the answer and the problem lies in the non-specificity of the SP24 antibody as highlighted buy several of you 
more specifically metastatic lobular carcinoma

more specifically metastatic lobular carcinoma

8/ Fun fact  Did you know that the well-known prostate-specific IHC marker NKX3.1 is positive in 25-28% av lobular breast carcinomas also? Say what
Did you know that the well-known prostate-specific IHC marker NKX3.1 is positive in 25-28% av lobular breast carcinomas also? Say what 
 Did you know that the well-known prostate-specific IHC marker NKX3.1 is positive in 25-28% av lobular breast carcinomas also? Say what
Did you know that the well-known prostate-specific IHC marker NKX3.1 is positive in 25-28% av lobular breast carcinomas also? Say what 
9/ What other tumors, except for prostate adenocarcinoma and lobular breast carcinoma, do you know to be positive for NKX3.1 IHC?  #IHCpath #breastpath
#IHCpath #breastpath
 #IHCpath #breastpath
#IHCpath #breastpath

 Read on Twitter
Read on Twitter